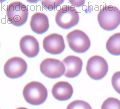
normaler_Blutausstrich_120x100.jpg

Einteilungen (Klassifizierungen) von Anämien
Autor: Prof. Dr. Stefan Eber, Ingrid Grüneberg, Redaktion: Ingrid Grüneberg, Freigabe: Prof. Dr. Ursula Creutzig, Zuletzt geändert: 24.04.2019 https://kinderblutkrankheiten.de/doi/e185441
Inhaltsverzeichnis
Einteilung von Anämien - Einführung
Um herauszufinden, was die Ursache einer Anämie ist, oder um diese zumindest einzugrenzen, ist die Bestimmung der Größe eines roten Blutkörperchens hilfreich. Bestimmte Laborwerte, die sogenannten Erythrozytenindizes MCV, MCH und MCHC, werden hierzu verwandt. Die durchschnittliche Größe (Volumen) eines Blutkörperchens wird als MCV (Mean Corpuscular Volume) ausgedrückt, dem mittleren Zellvolumen. Abhängig von Alter und Geschlecht des Patienten sind Normalbereiche (Referenzintervalle) definiert. Bei einer Anämie können diese Zellvolumen im Vergleich zum Normalbereich zu klein oder zu groß, aber auch normal groß sein. Zur weiteren Abklärung werden noch Laborwerte über den Gehalt (Hämoglobinwert MCH) und die Konzentration (MCHC) des roten Blutfarbstoffs hinzugezogen.
Eine weitere Unterteilungsmöglichkeit von Anämien sind die Art der Störungen bei der Bildung einer roten Blutzelle als auch bei deren Abbau (Hämolyse). Anämien werden auch unter dem Gesichtspunkt, ob sie angeboren oder erworben sind, eingeteilt.
|
Abk. |
Englische Bezeichnung |
Deutsche Bezeichnung |
Einheit |
|---|---|---|---|
|
MCV |
mean cell volume |
mittleres Volumen eines einzelnen Erythrozyten |
fl |
|
MCH |
mean corpuscular haemoglobin |
mittlerer Hämoglobin-Gehalt eines einzelnen Erythrozyten |
pg/Zelle |
|
MCHC |
mean corpuscular haemoglobin concentration |
mittlere Hämoglobin-Konzentration eines einzelnen Erythrozyten |
g/dl |
Einteilung nach der Größe der roten Blutkörperchen
Zu kleine rote Blutkörperchen - Mikrozytäre Anämie

Laborwerte MCV (Volumen) und MCH (Hämoglobin-Gehalt) sind vermindert.
Zu kleine rote Blutkörperchen eines Patienten mit Eisenmangel. Wegen des Eisenmangels weisen die Zellen zu wenig Hämoglobin (roten Blutfarbstoff) auf. Die Blutkörperchen sind nur schwach oder ringförmig gefärbt.
Mikrozytäre hypochrome Anämien (hypochrom - schwache Intensität der roten Farbe) sind typisch bei:
Zu große Blutkörperchen - Makrozytäre Anämien

Laborwerte MCV (Volumen) und MCH (Hämoglobin-Gehalt) sind erhöht
Links normal große, rechts ein zu großes rotes Blutkörperchen, ein sogenanntes Megalozyt.
Makrozytäre hyperchrome Anämien (hyperchrom - verstärkte Intensität der roten Farbe) können verursacht werden durch:
- Vitamin B12-Mangel
- Folsäuremangel
- myelodysplastisches Syndrom
Normal große Blutkörperchen - normozytäre Anämie
Laborwerte MCV (Volumen) und MCH (Hämoglobin-Gehalt) sind normal
Normal große rote Blutkörperchen mit normalem Gehalt des roten Blutfarbstoffs.
Normozytäre, normochrome Anämien (normochrom - normale Intensität der roten Farbe) treten auf bei:
- Blutung (Verlust von roten Blutkörperchen)
- Hämolyse (verstärkter Abbau von roten Blutkörperchen)
- Aplastischer Anämie
- Renaler Anämie (Anämie aufgrund einer akuten oder chronischen Nierenerkrankung)
Einteilung nach der Ursache
Eine weitere Unterteilung von Anämien wird nach speziellen Funktionsstörungen der roten Blutzelle vorgenommen.
Jede Blutzelle wird im Knochenmark gebildet und tritt dann in den Blutkreislauf ein. Nach einer bestimmten Lebensdauer wird die einzelne Blutzelle wieder abgebaut. In diesem Prozess können Störungen bei der Blutbildung und dem Blutabbau (Hämolyse) auftreten.Starke Blutungen können ebenfalls zu einer Blutarmut führen.
Bildungstörungen bei roten Blutzellen
Bildungsstörungen bei roten Blutkörperchen (Erythrozyten) können unterschiedliche Ursachen haben. Eine Knochenmarkerkrankung kann zu einer deutlichen Verminderung der blutbildenden Stammzellen führen wie bei der Aplastischen Anämie. Auch können Mängel an Stoffen, die zur Bildung der roten Blutkörperchen oder des roten Blutfarbstoffs notwendig sind, vorliegen. Hierzu zählen ein Eisenmangel oder Mangel an Vitamin B12. Bei einer chronischen Nierenerkrankung oder nicht funktionstüchtigen Nieren liegt ein Mangel des Wachstumsfaktors Erythropoetin vor. Erythropoetin wird hauptsächlich in der Niere produziert. Folgende Anämien gehören dazu:
- Aplastische Anämie
- Eisenmangelanämie
- Angeborene dyserythropoetische Anämien (Congenital Dyserythropoetic Anaemias, CDA)
- Renale Anämie (lat. Ren = Niere)
Gesteigerter Abbau von roten Blutzellen (Hämolyse)
Korpuskuläre hämolytische Anämien
Die Ursache für den gesteigerten Abbau von roten Blutzellen liegt bei den Erythrozyten selbst. Dazu zählen Defekte an der Zellmembram des roten Blutkörpchens oder bestimmte Störungen bei einzelnen Blutbestandteilen. Bei Hämoglobinopathien liegen Defekte beim roten Farbstoff vor. Die korpuskulären Anämien sind zumeist angeboren. Zu diesen zählen:
Extrakorpuskuläre hämolytische Anämien
Die Ursache für den gesteigerten Abbau von roten Blutzellen liegt außerhalb der Erythrozyten. Autoimmunkrankheiten wie auch Virusinfektionen oder bestimmte Arzneimittel können zur Hämolyse führen. Eine solche Anämieform ist:
Blutung (Erythrozytenverlust)
Akute oder chronische Blutverluste können dazu führen, dass der Verlust an Erythrozyten größer ist als deren Neubildung. Akute schwere Blutungen können bei Verletzungen oder Operationen entstehen. Chronische Blutverluste treten bei Magengeschwüren oder schweren Regelblutungen auf.
Einteilung nach angeborenen oder erworbenen Anämien
Angeborene Formen
Bei den angeborenen Formen der Blutarmut liegen meist krankhafte Veränderungen von Genen vor, die bei der Blutbildung eine wichtige Rolle spielen. Zu solchen genetischen Defekten kommt es oft im Zusammenhang mit bestimmten Erbkrankheiten. Die weltweit häufigste angeborene Form der Blutarmut, die bei Kindern und Jugendlichen mit weiteren gesundheitlichen Problemen einhergeht, ist die Sichelzellkrankheit. Angeborene Anämien sind:
Diamond-Blackfan-Anämie
Dyserythropoetische Anämie
Fanconi-Anämie
Kugelzellenanämie
Sichelzellkrankheit
Thalassämie
Erworbene Formen
Bei den erworbenen Formen können der Mangel an bestimmten Vitaminen wie Vitamin B12, Blutverluste, schwere Nierenerkrankungen, eine Schilddrüsenunterfunktion, einige Krankheitserreger, manche Medikamente oder auch bösartige Erkrankungen im Laufe des Lebens zu Störungen der Blutbildung führen und dadurch eine Blutarmut erzeugen.
Die weltweit häufigste erworbene Form der Blutarmut bei Kindern und Jugendlichen ist die Eisenmangelanämie. Erworbene Anämien sind:
Anämie bei chronischen Erkrankungen
Autoimmunhämolytische Anämie
Eisenmangelanämie

